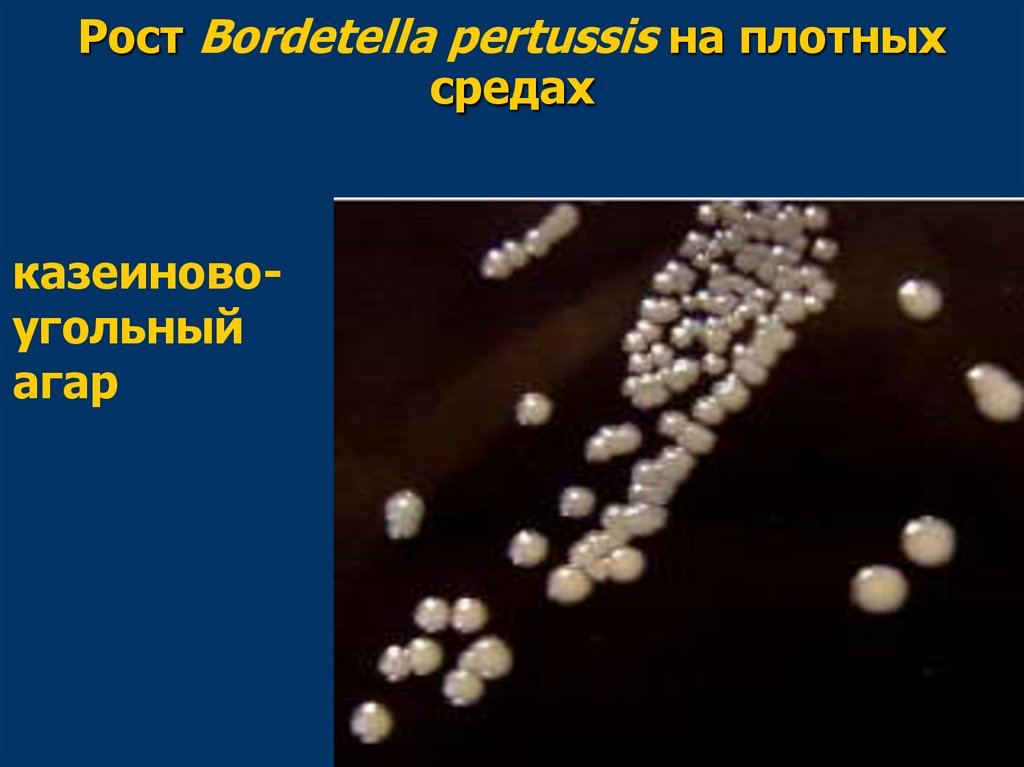
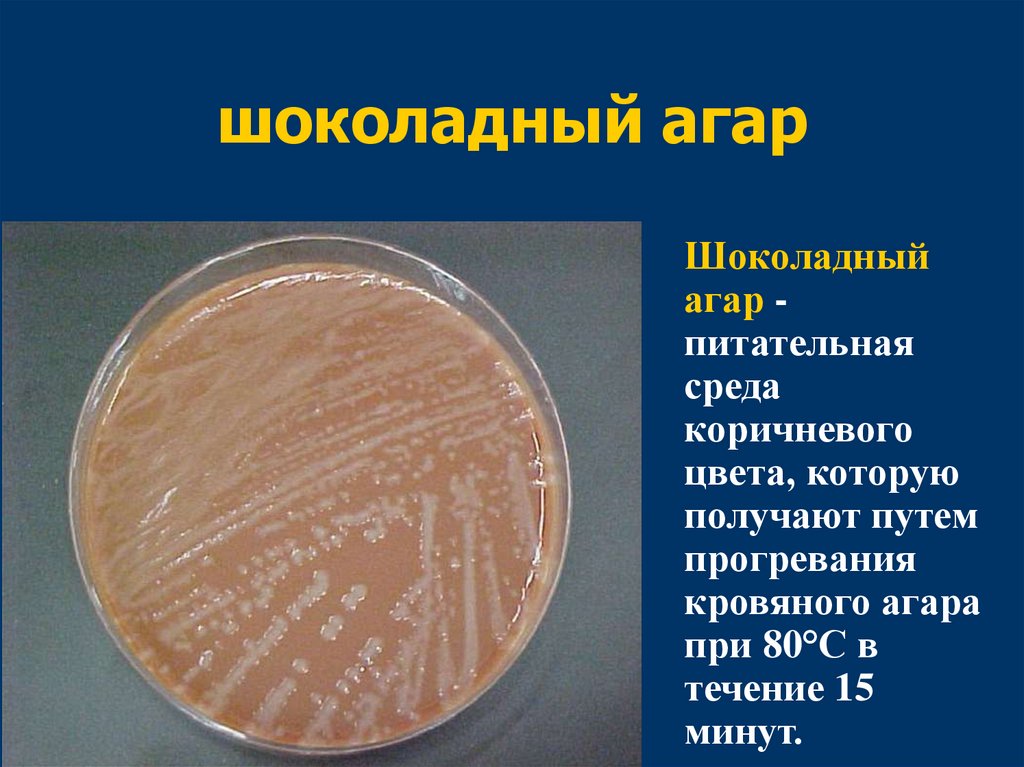

Similar presentations:
Некишечные грамотрицательные палочки
1. Некишечные грамотрицательные палочки
УРАЛЬСКИЙ ГОСУДАРСТВЕННЫЙ МЕДИЦИНСКИЙ УНИВЕРСИТЕТКАФЕДРА МИКРОБИОЛОГИИ, ВИРУСОЛОГИИ И ИММУНОЛОГИИ
Некишечные
грамотрицательные палочки
2.
Возбудитель коклюша3.
Коклю́ш – остроеинфекционное заболевание
дыхательных путей,
основным
симптомокомплексом
которого являются
приступы судорожного
кашля
4. Bordetella pertussis
Жюль Борде1906
Октав Жангу
5.
Семейство –Alcaligenaceae
Возбудитель -
Bordetella pertussis
6. Биологические свойства
7. Биологические свойства
короткие палочки овоиднойформы
грамотрицательные
окрашиваются биполярно за
счет зерен волютина
неподвижны
спор не образует
облигатные аэробы
8. Bordetella pertussis
9. Bordetella pertussis
10. Bordetella pertussis
Средами для выделениявозбудителя являются:
11. Bordetella pertussis
Средами для выделениявозбудителя являются:
картофельно-глицериновый
агар с добавлением крови
(среда Борде - Жангу)
полусинтетическая среда
казеиново-угольный агар (КУА)
12.
Рост Bordetella pertussis на плотныхсредах
Рост на среде
Борде-Жангу
13.
Рост Bordetella pertussis на плотныхсредах
казеиновоугольный
агар
14. Биохимическая активность
B. pertussis выражена слабо.Возбудитель коклюша не
ферментирует сахара, не редуцирует
нитраты, не обладает
протеолитической активностью.
Бордетеллы продуцируют каталазу,
гиалуронидазу, коагулазу,
лецитиназу.
15. Антигенная структура
У бордетелл выделяют соматический термостабильный Оантиген и поверхностные термолабильные капсульные Кантигены или агглютиногены (так называемые факторы 116).Фактор 7 является общим для всех бордетелл (общеродовой
агглютиноген), фактор 1 характерен для B. pertussis, фактор
14 – для B. parapertussis, фактор 12 – для B. bronchiseptica
(видовые агглютиногены).
Видовые агглютиногены используются для получения
монорецепторных сывороток, позволяющих
дифференцировать представителей рода Bordetella.
16. Резистентность
Возбудитель коклюша вне организма быстро погибает (втечение нескольких часов).
В сухой мокроте он сохраняется в течение нескольких
часов, в капельках аэрозоля – в течение 20-23 часов.
B. pertussis обладает высокой чувствительностью к
действию ультрафиолетовых лучей, дезинфицирующих
веществ и повышенной температуры. Под влиянием
прямых солнечных лучей возбудитель погибает в течение 1
часа.
Возбудитель коклюша обладает чувствительностью к
полимиксину, стрептомицину, тетрациклину, биомицину,
но устойчив к пенициллину и сульфаниламидам.
17. Факторы вирулентности
Факторы адгезии:фимбриальные агглютиногены (нитевидные
выросты на поверхности бактерий, к
которым в организме вырабатываются
специфические антитела - агглютинины);
филаментозный гемагглютинин
(поверхностный белок палочковидной
формы);
белок наружной мембраны пертактин.
18. Факторы вирулентности
Токсины бордетелл:эндотоксин (липополисахарид);
коклюшный экзотоксин (пертуссис-токсин);
внеклеточная аденилатциклаза
(аденилатциклазный токсин-гемолизин);
трахеальный цитотоксин;
термолабильный дермонекротический
токсин (дермонекротоксин);
19. Эпидемиология
Источник инфекции:больной человек типичной и
стертой формами
Механизм передачи:
- аэрогенный
Путь передачи:
-воздушно-капельный
20. Патогенез
Входными воротами для возбудителякоклюша являются слизистые оболочки
верхних дыхательных путей (гортани,
трахеи, бронхов).
Бордетеллы не проникают внутрь клетки и
не поступают в кровь (при коклюше
отсутствует бактериемия).
Они обладают тропизмом к клеткам
реснитчатого эпителия.
21.
Размножение коклюшных палочек намерцательном эпителии
22. Патогенез
В патогенезе коклюша выделяют следующие стадии.Первая стадия – адгезия возбудителя на клетках
реснитчатого эпителия слизистой оболочки верхних
дыхательных путей с последующей колонизацией эпителия.
Возбудитель, попав в дыхательные пути, с помощью
филаментозного гемагглютинина, пертактина,
фимбриального агглютиногена прикрепляется к ресничкам
мерцательного эпителия.
На поверхности ресничек эпителиальных клеток происходит
размножение возбудителя (колонизация слизистой), в
результате чего нарушаются функции клеток эпителия.
23. Патогенез
В патогенезе коклюша выделяют следующие стадии.Вторая стадия – местное повреждение тканей токсинами
микроба. После адгезии происходит размножение
возбудителя на поверхности клеток эпителия (колонизация
слизистой оболочки) и выделение трахеального
цитотоксина, коклюшного токсина, аденилатциклазного
токсина и дермонекротического токсина. Трахеальный
цитотоксин вызывает паралич ресничек мерцательного
эпителия, в результате чего нарушается отток слизи с
поверхности мерцательного эпителия. Аденилатциклазный
токсин обусловливает развитие воспалительных явлений и
возникновение очагов некроза.
24.
Стадия системных проявленийВ результате некротических поражений
эпителия происходит постоянное
раздражение рецепторов афферентных
волокон блуждающего нерва.
Возбуждение передается в кашлевой центр
продолговатого мозга, в результате этого
развивается основной симптомокомплекс
коклюша – приступы судорожного кашля.
25. периоды заболевания
26. периоды заболевания
Инкубационный –продолжительность от 5 до 21-го
дня (в среднем 7-10 дней).
Катаральный - продолжительность
около двух недель.
Конвульсивный (судорожный) продолжительность 4-6 недель
Угасания – продолжительность
периода – 2-3 недели.
27. Лабораторная диагностика
Основным является бактериологическийметод
Исследуемый материал: секрет дыхательных
путей (носоглотки, трахеи, бронхов).
Материал берут методом “кашлевых
пластинок” или с помощью тампона с задней
стенки глотки.
Иммунофлуоресцентный метод
Серологические методы (РА, РНГА, РСК)
ПЦР
28. Лечение
Проведение антибактериальнойтерапии (эритромицин,
тетрациклин, левомицетин) в
катаральный период.
В конвульсивный период
антибиотики не оказывают
влияния на течение заболевания.
29. Профилактика
Цельноклеточные вакцины:АКДС (Россия);
Бубо-Кок (Россия);
Тетракок (Франция);
Тританрикс (Англия).
Бесклеточные (ацеллюлярные) вакцины:
Инфанрикс (Англия);
Гексавак (Франция);
Пентавак (Франция);
Триацелювакс (Германия).
30.
В России зафиксирован резкий ростзаболеваемости коклюшем.
В 2019 году заболевание выявили у 14
тыс. 406 граждан. Это почти на 40%
больше, нежели в 2018 году.
С января 2020 года диагноз был
поставлен у 1758 россиян.
Большинство из них (89%) – это дети и
подростки до 14 лет.
31.
Возбудитель паракоклюшаBordetella paraрertussis
32.
Паракоклюш чаще возникает у детей 3-6 лет.Инкубационный период при паракоклюше
составляет 1-2 недели.
Клинически паракоклюш проявляется как
легкая форма коклюша.
Заболевание сопровождается ринитом,
гиперемией зева, субфебрильной
температурой, кашлем.
Лечение паракоклюша проводится с
помощью симптоматических средств.
В связи с легким течением заболевания
антибиотики не используют.
33.
Гемофильные бактерии34.
СемействоРод
Pasteurellaceae
Haemophilus
H. influenzae
35. H. influenzae
мелкие (овоидные)грамотрицательные палочки,
неподвижны,
спор не образуют,
имеют пили (фимбрии),
вирулентные штаммы гемофильной
палочки образуют полисахаридную
капсулу.
36. H. influenzae
Способны расти только наобогащенных питательных средах,
содержащих кровь или ее производные
в качестве факторов роста.
Для культивирования гемофильной
палочки применяют шоколадный агар.
Гемолитической активностью не
обладают.
37. шоколадный агар
Шоколадныйагар питательная
среда
коричневого
цвета, которую
получают путем
прогревания
кровяного агара
при 80°С в
течение 15
минут.
38. H. influenzae
Вирулентные капсульные штаммыобразуют крупные слизистые колонии
(3-4 мм в диаметре) S-формы.
Слабовирулентные бескапсульные
варианты гемофильной палочки
образуют R-колонии - более мелкие
(около 1 мм), мелкозернистые, с
неровными краями.
39. Факторы патогенности
Ведущим фактором вирулентности H.influenzae - является полисахаридная
капсула, которая защищает бактерии от
фагоцитоза, обеспечивает выживаемость
бактерий в организме и способствует
распространению инфекции.
sIgA-протеаза, способная инактивировать
секреторные антитела.
Пили (фимбрии).
Экзотоксины H. influenzae не продуцирует.
40. Антигенные свойства
H. influenzae обладают соматическимО-антигеном и капсульным
полисахаридным К-антигеном.
В зависимости от особенностей
строения капсульного антигена
различают 6 серотипов H. influenzae
(а, b, с, d, е, f).
Капсульный антиген гемофильной
палочки серотипа b, имеет
наибольшее значение в патологии
человека.
41. Эпидемиология
Источником инфекции являютсябольные люди или бактерионосители.
Путь передачи - воздушно-капельный.
42. Патогенез
Проникает через верхние дыхательныепути.
Прикрепляется к мерцательному эпителию
и колонизирует его.
Бескапсульные варианты гемофильных
бактерий часто остаются во входных
воротах инфекции, не вызывая симптомов
заболевания (бессимптомное носительство).
У людей со сниженным иммунитетом они
способны проникать в подслизистый слой и
вызывать - отиты, синуситы (воспаление
придаточных пазух носа), ларинготрахеиты,
бронхиты, пневмонии.
43. Патогенез
Капсульные варианты гемофильной палочкимогут распространяться в организме
гематогенно, вызывая септицемию,
септический артрит, эндокардит.
После проникновения через
гематоэнцефалический барьер, они
вызывают тяжелые гнойные менингиты.
Гнойный менингит, вызванный H. influenzae,
заканчивается летально в 5% случаев, даже
при проведении адекватной терапии.
44.
Болезни, вызываемые H. influenzae,могут быть инвазивными:
гнойный менингит,
пневмония,
септический артрит,
остеомиелит,
бактериемия.
И неинвазивными:
отит,
синусит,
конъюнктивит.
45. Микробиологическая диагностика
Материал для исследования - слизьиз носоглотки, кровь, содержимое
очагов поражения, мокрота или
ликвор, при септических артритах суставная жидкость.
46. Методы диагностики
Серологические тесты с цельюобнаружения b-капсульного антигена
H. influenzae: прямая РИФ или
реакция латекс-агглютинации.
ПЦР, ИФА.
47. Методы диагностики
Культуральный метод исследования.Посев для выделения гемофилов
производят на шоколадный или кровяной
агар.
Инкубирование проводят в течение 24-48
часов.
H. influenzae дифференцируют от других
близкородственных грамнегативных
палочек.
Для чистой культуры гемофильной палочки
характерно наличие специфического
“мышиного” запаха.
48. Лечение
Проводят с помощью антибиотиков.Для антимикробной терапии “гемофильного
менингита” важным принципом выбора
антибиотика является его способность
накапливаться в ликворе.
В отсутствие адекватного лечения уровень
летальных исходов составляет около 90%,
причем смерть может наступить в первые 24
часа от начала заболевания.
Поэтому лечение назначают эмпирически до
получения результатов антибиотикограммы.
49. Профилактика
Для повышения эффективности вакцинациипротив H. influenzae b-инфекции предложено
использовать конъюгированные вакцины,
содержащие антигены возбудителя на
белке-носителе.
В качестве таких носителей применяют
дифтерийный либо столбнячный
анатоксины, или белки наружной мембраны
менингококка группы В (комбинированная
вакцина для профилактики
менингококкового и гемофильного
менингитов).
50. Пентаксим
Вакцина для профилактикидифтерии и столбняка
адсорбированная, коклюша
ацеллюлярная, полиомиелита
инактивированная, инфекции,
вызываемой Haemophilus
influenzae тип b, конъюгированная.
51. Haemophilus influenzae биовар aegyptius
H. influenzae биовар aegyptius (H. aegyptius) былвыделен Р. Кохом в 1883 г. в Египте от больного с
гнойным конъюнктивитом. Эти бактерии принято
называть “бацилла Коха-Уикса” или “ H. influenzae
биотип III”.
Морфологические, тинкториальные и
культуральные свойства этих бактерий не
отличаются от таковых H. influenzae.
Эпидемиология, клиника. H. influenzae биовар
aegyptius вызывает распространенный повсеместно
гнойный конъюнктивит с высокой контагиозностью.
Передается от человека к человеку контактным
путем через грязные руки, полотенце, контактные
линзы и т.д.
52. Haemophilus influenzae биовар aegyptius
Диагностика. При конъюнктивите исследуют мазоксо слизистой оболочки глаз или гнойное
отделяемое.
Применяют бактериоскопический и культуральный
методы исследования. Идентификацию возбудителя
проводят с помощью реакции агглютинации со
специфической сывороткой.
Для лечения применяют антибиотики, при
конъюнктивите антибиотики назначают местно мази и глазные капли с тетрациклином,
аминогликозидами и сульфаниламидами.
Специфическая профилактика не разработана.
53. Haemophilus ducreyi
Возбудитель мягкого шанкра былподробно описан итальянским
венерологом А. Дюкре (1890 г.).
Мягкий шанкр - это венерическое
заболевание, симптомы которого
напоминают сифилис.
Источником инфекции является
больной человек.
Механизм заражения – контактный.
Путь инфицирования - половой и
контактно-бытовой.
54. Haemophilus ducreyi
Инкубационный период составляет 3-5 дней,однако первые симптомы заболевания
(красное пятно в месте проникновения
возбудителя) можно наблюдать уже в
первые сутки после инфицирования.
Регионарные лимфоузлы увеличены и
болезненны.
Мягкий шанкр отличается от твердого
шанкра при сифилисе болезненностью при
пальпации и кровоточивостью.
Иммунитет после перенесенного
заболевания не вырабатывается.
55. Haemophilus ducreyi
Микробиологическая диагностика основанана обнаружении мелких грамотрицательных
палочек в отделяемом из язвы, обычно в
ассоциации с другими гноеродными
микробами.
На шоколадном агаре Н. ducreyi образуют
мелкие сероватые колонии без гемолиза.
Лечение проводят с помощью антибиотиков.
Специфическая профилактика не
разработана.
56.
Синегнойная палочка(Pseudomonas aeruginosa)
57.
Синегнойная палочка являетсянаиболее частым возбудителем
внутрибольничных инфекций.
Этим микроорганизмом обусловлено
16% внутрибольничных пневмоний,
12% внутрибольничных инфекций
мочевыводящих путей, 8% инфекций
хирургических ран.
Она является ведущим условнопатогенным микроорганизмом в
отделениях реанимации и
интенсивной терапии (ОРИТ).
58.
PseudomonadaceaeРод Pseudomonas (150 видов).
Семейство
Основным видом,
вызывающим инфекции у
человека, является -
P. aeruginosa
59. Морфологические и тинкториальные свойства
Грамотрицательная палочка.Подвижность обеспечивается наличием
одного (монотрихи) или двух полярно
расположенных (амфитрихи) жгутиков.
Спор не образует.
Истинной капсулы нет,
только
капсулоподобная оболочка в виде слизи.
60. Культуральные свойства
Являются облигатными аэробами.Растут на простых питательных средах.
При росте синегнойной палочки на МПА
питательная среда окрашивается в сине-зеленый
цвет.
Колонии S- формы гладкие сухие или слизистые у капсульных штаммов.
На кровяном агаре вокруг колоний синегнойной
палочки наблюдаются зоны гемолиза.
В жидкой питательной среде (МПБ) образуют
серовато-серебристую пленку на поверхности и
вызывают помутнение и сине-зеленое
окрашивание среды.
61. Рост P. aeruginosa в жидкой и на плотной питательной среде
62. Антигенные свойства
О- и Н-антигены.Родовой О- антиген – ST
липополисахарид клеточной стенки
(20 серогрупп).
Н-антиген -LT (10 серогрупп).
Капсулоподобная внеклеточная слизь
является капсульным К-антигеном
мукоидных штаммов.
63. Факторы патогенности
Жгутики, пили.Липид А.
Капсулоподобная оболочка
обеспечивает защиту бактерий от
фагоцитоза и устойчивость к ряду
антибиотиков.
64. Факторы патогенности
Ферменты агрессии:Нейраминидаза принимает участие в
колонизации респираторного тракта,
разрушая муцин на поверхности
слизистых оболочек.
Коллагеназа вызывает гидролиз
коллагена соединительной ткани.
Липаза и фосфолипаза разрушают
мембраны эритроцитов и других клеток
организма.
65. Экзотоксины
P. aeruginosa продуцируеет два классаэкзотоксинов:
экзотоксин А (ExoA),
4 варианта “контактных”
экзотоксинов, которые
высвобождаются с помощью системы
секреции III типа непосредственно в
цитоплазму клетки-мишени (ExoS,
ExoT, ExoU и ExoY).
Экзотоксины поражают клетки нашего
организма, что приводит к некрозам и
кровоизлияниям.
66. Резистентность
P. aeruginosa характеризуется высокойустойчивостью к антибиотикам, что
объясняется плохой проницаемостью
ее клеточной стенки и способностью
синтезировать пенициллиназу.
Чувствительна к высушиванию,
действию хлорсодержащих
дезинфицирующих препаратов,
раствора перекиси водорода, раствора
фенола и высоких температур.
67. Клиническая картина
Выделяют инфекции:желудочно-кишечного тракта (острый
энтероколит, гастроэнтероколит),
мочевыводящих путей (цистит, уретрит,
пиелонефрит),
дыхательной системы (бронхит,
муковисцидоз),
мягких тканей и кожи (раневые инфекции,
ожоговая болезнь),
уха, глаз,
нервной системы (менингиты).
68. Клиническая картина
Вызывает инфекционные заболеванияпреимущественно у лиц с
иммуносупрессией.
Имеет склонность к хроническому
течению.
Летальность от синегнойного сепсиса
достигает 50%.
69. Эпидемиология
Источник инфекции – человек.Возможно как эндогенное, так и
экзогенное инфицирование.
Резервуар инфекции - увлажнители,
аппараты искусственной вентиляции
легких, ингаляторы, эндоскопическая
аппаратура и др.
70. Эпидемиология
Механизмы заражения - контактный,аэрогенный, парентеральный,
фекально-оральный.
Пути заражения – контактно-бытовой,
контактно-инструментальный,
имплантационный, воздушнокапельный, водный, пищевой.
71. Эпидемиология
Высокий риск развития синегнойнойинфекции отмечается в ожоговых
центрах, хирургических отделениях,
акушерских стационарах.
Группа повышенного риска -
пациенты, подвергающиеся
иммуносупрессивной терапии,
новорожденные, лица пожилого
возраста.
72. Микробиологическая диагностика
Материал для исследования: кровь (присептицемии), спинномозговая жидкость (при
менингите), гной и раневое отделяемое (при
инфицированных ранах и ожоговых
поражениях), моча (при инфекциях
мочевыводящих путей), мокрота (при
инфекциях респираторного тракта).
Бактериоскопическое исследование мазков из
исследуемого материала мало информативно.
73. Микробиологическая диагностика
Основной метод - бактериологическоеисследование.
При идентификации P. aeruginosa учитывают
пигментообразование, наличие характерного
специфического запаха культуры,
положительный тест на цитохромоксидазу,
выявление термофильности (рост при 42 ОС и
отсутствие роста при 5ОС).
Для внутривидовой идентификации бактерий
проводят серотипирование,
пиоцинотипирование, фаготипирование.
74. Микробиологическая диагностика
Серологическое исследование:проводят методом агглютинации на
стекле с использованием набора
поливалентных сывороток к Оантигенам.
РСК, РПГА - для обнаружения
специфических антител к антигенам
синегнойной палочки.
75. Неспецифическая профилактика
Основные меры в стационаре:Качественная стерилизация,
дезинфекция и антисептика, а также
соблюдение правил асептики.
Контроль обсемененности внешней
среды (воздуха, различных предметов,
инструментов и аппаратуры).
Соблюдение правил личной гигиены.
76. Специфическая профилактика
Псевдовак - из структурных и внеклеточныхантигенов инактивированных нагреванием
штаммов, принадлежащих к 7 иммунотипам P.
аeruginosa. Детям с 1 месяца и взрослым.
Стафило-протейно-синегнойная
адсорбированная вакцина.
Активная иммунизация против инфекций,
вызываемых P. aeruginosa, показана больным
из групп риска (больным с муковисцидозом,
диабетом, а также иммунодефицитным
лицам).
77. Лечение
Антибиотики из разных групп, из-заналичия резистентности ко многим
антибиотикам.
При тяжелых формах используют
гипериммунную плазму от доноров
иммунизированных синегнойной
вакциной.
При местном лечении применяют
синегнойный бактериофаг.
78. Дома
Грамотрицательные палочки –возбудители опасных зоонозных
инфекций –
Yersinia pestis,
Francisella tularensis,
Brucella spp.

medicine
medicine








